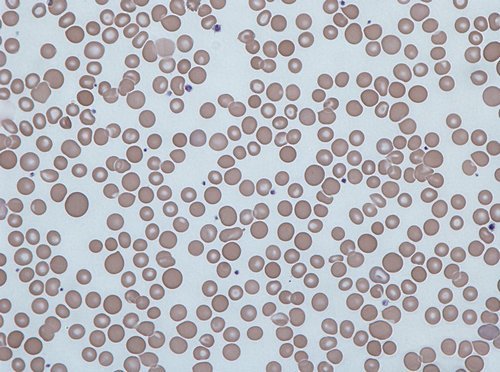
A severe type of anisocytosis

Definition
Anisocytosis is a condition in which the red blood cells are unequal in size. It is common in people suffering from anemia, thalassemia, and other types of blood cell disorders.
It comes from the word “aniso” which means dissimilar or unequal and “cytosis” meaning movement of or features of cells. Anisocytosis represents a serious underlying blood-related condition.
Why having uneven red blood cells is a problem?
It is important for red blood cells to be ideal in sizes and shapes for them to transport oxygen smoothly to different parts of the body. If they are uneven in sizes and shapes, the oxygen transport system will not work efficiently.
If the red blood cells are abnormal in shapes, the condition is called poikilocytosis. The normal shape of red blood cell is flat and circular. The border is fatter than the middle portion. If the irregularly shaped red blood cells is more than 10% of the total population of red blood cells, a patient is suffering from poikilocytosis.
Any abnormality in the red blood cells can be easily felt by the body. If the red blood cells is deficient in haemoglobin, the body will suffer from a condition called anemia.
If there is insufficient color or pigmentation in RBC, a mild anisocytosis is possible, which is quite common in pregnant women. It is one of the reasons why pregnant women are advised to increase their intake of iron-rich foods and take iron supplements.

Image 1 : A microscopic image of abnormal red blood cells
Picture Source : s-media-cache-ak0.pinimg.com
Picture 2: A severe type of anisocytosis
Image Source : upload.wikimedia.org
Signs and Symptoms of Anisocytosis
- You easily get tired even without exerting much effort.
- Your body lacks energy.
- You are short of breath because of inefficient oxygen supply in the body.
- The heart rate increases for no apparent reason. It is the heart’s way of coping for lack supply of red blood cells.
- Noticeable pale skin, especially in the fingers and nails, lips, and face.
Causes of Anisocytosis
- Iron deficiency – iron is required to make blood. If the body lacks iron, the production of red blood cells will be reduced significantly. Over time, it could lead to anemia and anisocytosis.
- Vitamin A deficiency – Vitamin A is needed by the body to fight diseases. If the body lacks vitamins A, red blood cell’s size will be affected. It could lead to irregular sized RBCs leading to anisocytosis.
- Vitamin B12 deficiency – Vitamin B12 is another important component for red blood cell production. Lack of vitamin B12 can lead to pernicious anemia that when gets severe could lead to anisocytosis.
- Myelodysplastic syndrome – It affects the blood, especially the bone marrow thereby leading to formation of irregular sized red blood cells.
- Blood transfusion – It is one of the reasons for anisocytosis. The size of the red blood cells in the transfused blood should be the same as the patient’s red blood cells.
- Patients with chronic liver disease are susceptible to anisocytosis.
- Inherited blood disorders like thalassemia
- Patients are susceptible to anisocytosis if they have disease like haemoglobin H disease and Kwahiorkor disease.
How to diagnose Anisocytosis?
- Blood Test – A blood sample is required to diagnose anisocytosis. The blood smear will be checked under a microscope to reveal irregularity in size of the cells. To determine the degree of anisocytosis, a red blood cell distribution width (RDW) examination is done.
- MCV (Mean Cell Volume) – This test gives an accurate red blood cell count.
From the above-mentioned tests, the degree of anisocytosis is determined. A +1 anisocytosis is diagnosed if the red blood cells are low in number. A +2 anisocytosis is diagnosed if the number of irregularly sized red blood cells is greater.
Anisocytosis representing a symptom of another problem
- High volume of smaller red blood cells – it suggests that you have low iron in the blood. It could also be an indicative of sickle cell anemia, although additional test should be carried out.
- High volume of large red blood cells – It indicates that a patient could be suffering from vitamin deficiencies, live disease, and hyperthyroidism.
- More normal red blood cells than the abnormal cells – Abnormal red blood cells, although small in number still suggest an underlying health problem. It could be an early onset of vitamin deficiency or other types of anemia.
Treatment
The causes of anisocytosis vary from one person to another. Hence, there is no particular cure for the disease. It depends on the root cause of the problem. Keep in mind that anisocytosis is not a disease itself, but a symptom of an underlying health problem. If anisocytosis is caused by vitamin deficiency, then the patient should take vitamin supplement.
Below are the recommended treatment management for Anisocytosis
- Taking supplements – The patient is advised to start taking supplements rich in essential vitamins and minerals, especially iron and vitamin B12.
- Diet modification – A change in diet is highly advised. Increase your intake of foods rich in iron and essential vitamins.
- Blood transfusion – If the anisocytosis is severe, the doctor will order blood transfusion to filter out abnormal cells and replace them with normal cells.
What to keep in mind?
If you know someone who demonstrates the symptoms of anisocytosis, then you have to take the necessary actions immediately before the condition gets worst. You have to consult a health care professional right away.
You also need to evaluate your diet. Modern day diet lacks essential nutrients. When it comes to blood-related symptoms, you have to increase your intake of foods rich in iron, vitamin A, and vitamin B12.
Strictly adhere with the physician’s advice.If you can’t contact a medical professional at the moment, then the best thing to do is to evaluate the presence of anisocytosis at home. There are now over the counter test kits to help you evaluate the possibility of having anisocytosis.
These are the following:
-
Anemia Test Kit
-
Thyroid Gland Function Test
-
Calcium Deficiency Test
-
Adrenal Gland Function Test
Keep in mind that these tests suggest possibility of having problems in the red blood cells. Any abnormalities suggest that you have to consult your doctor immediately before the problem gets worst.
Make it a habit to see your doctor regularly to monitor your health condition and treat underlying problem at an early stage.
References:
- https://en.wikipedia.org
- www.hxbenefit.com
- www.rightdiagnosis.com
- www.ncbi.nlm.nih.gov/
- www.gpnotebook.co.uk
- http://healthool.com
- www.medicinenet.com
- www.healthboards.com
- Diagnostic Hematology By Norman Beck
- Primary Care Medicine: by Allan H. Goroll, Albert G. Mulley
